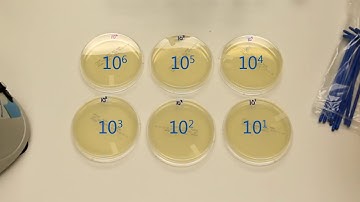
How to Perform Serial Dilutions in Microbiology

⬇ DOWNLOAD NOW
Kalau muncul iklan pop-up, tutup lalu klik tombol kembali
Download lagu How to Do a Serial Dilution (99mL bottles) - MCCC Microbiology secara gratis hanya untuk keperluan promosi. Dukung artis favorit kamu dengan membeli musik original di iTunes atau platform resmi lainnya.
 How to Do a Serial Dilution (9mL test tubes) - MCCC Microbiology
How to Do a Serial Dilution (9mL test tubes) - MCCC Microbiology
 How to prepare a Serial Dilution
How to prepare a Serial Dilution
 Serial Dilution
Serial Dilution
 Serial dilution | KAFT 348 General Microbiology Laboratory
Serial dilution | KAFT 348 General Microbiology Laboratory
 Inlabtec SD UA: How to perform Serial Dilutions in Microbiology in a new way.
Inlabtec SD UA: How to perform Serial Dilutions in Microbiology in a new way.
 58026 Serial Dilutions (v2)
58026 Serial Dilutions (v2)
 Serial dilutions 🧪🥼 #laboratory #science #microbiology
Serial dilutions 🧪🥼 #laboratory #science #microbiology
How to Perform Serial Dilutions in Microbiology
How to Perform Serial Dilutions in Microbiology